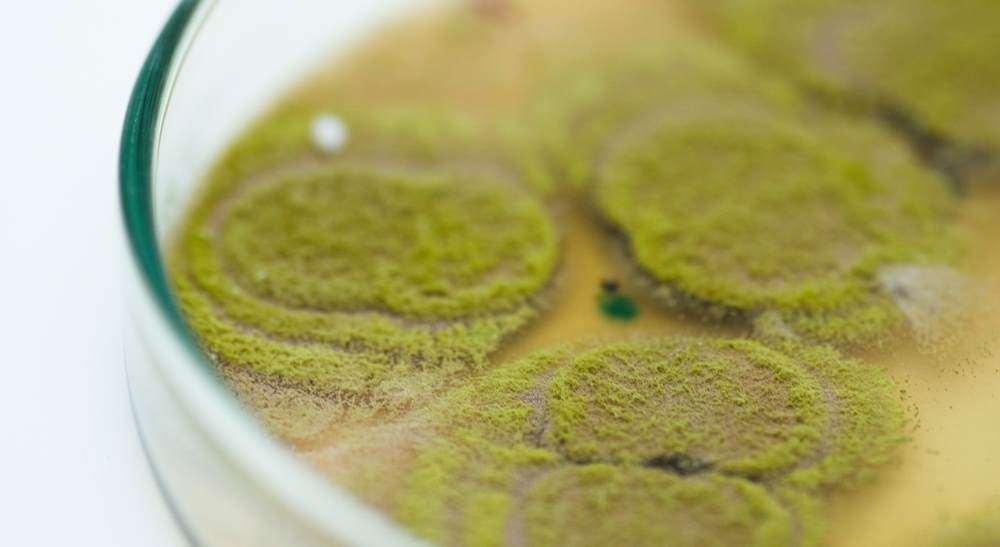
Petri dish with Trichoderma harzianum colonies on agar used to study microbial viability in biological formulation

Discover the latest news

The rise of chassis systems in oil dispersion development: innovation or illusion?
4 May 2026
Explore the rise of chassis systems in OD formulation development and understand how Cresmer OD SOL delivers superior stability, flexibility and performance.

Cresmer™ OD SOL: A high‑performance chassis for robust OD formulation
14 April 2026
Learn how Cresmer OD SOL simplifies OD formulation as an all-in-one chassis designed to deliver reliable performance across diverse actives.

Agriculture business review
24 March 2026
Discover how Croda is driving differentiation in Agriculture. Exploring innovation, market trends, and strategic growth driving performance in this year’s annual report business review.

Agriculture megatrends and market environment
24 March 2026
Agriculture trends are reshaping the industry, driving innovation to boost yields, navigate market volatility, and advance sustainable crop solutions.

Agriculture sustainability review
24 March 2026
Sustainability in Agriculture focuses on regenerative practices, innovative crop solutions that boost yields while reducing environmental impact, and supporting global food security.

Why rainfastness adjuvants matter in agriculture
4 March 2026
Unpredictable weather, tighter regulations, and growing demand are making it harder for crop protection products to perform as intended. Rainfall, in particular, can wash treatments away before...

Croda wins Bayer's Igniting Networks Decarbonization Excellence Award 2025
4 December 2025
Croda has been awarded the Igniting Networks Decarbonization Excellence Award 2025 during Bayer’s supplier event, Igniting Networks Live. This award honours partners who truly go the extra mile for...

Measure it to master it: harnessing biogenic carbon data for sustainable agriculture innovation
24 November 2025
Croda now provides Product Carbon Footprints for over 500 agricultural products from 12 global sites, helping you make smarter, lower-carbon choices. With biogenic and total carbon data included in...

The innovations helping to deliver Regenerative Agriculture
23 September 2025
Soil isn’t dirt—it’s life. Regenerative Agriculture revives tired soils, reduces damaging practices, and harnesses innovation to grow resilience from the ground up. Explore the full story now.

What is Regenerative Agriculture: A primer
23 September 2025
Explore how Regenerative Agriculture is reversing decline, rebuilding soil health, and restoring productivity—offering a roadmap for both sustainable farming and resilient agri-innovation.

Croda Agriculture and Incotec release whitepaper on regenerative agriculture
23 September 2025
Croda Agriculture and Incotec have released a whitepaper on regenerative agriculture. The whitepaper has the title ‘Regenerative Agriculture: How to improve natural ecosystems and increase yields’.
Maintaining microbial viability with high quality surfactants in biological formulations
26 June 2025
As biological agriculture grows, turning promising microbes into reliable products remains a challenge. Factors like microbial yield, survival, and shelf stability often hinge on something easily...





